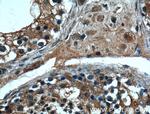
MSRB3 Antibody in Immunohistochemistry (Paraffin) (IHC (P))
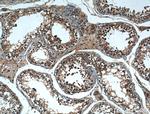
MSRB3 Antibody in Immunohistochemistry (Paraffin) (IHC (P))

Search
Proteintech
MSRB3 Polyclonal Antibody
{{$productOrderCtrl.translations['antibody.pdp.commerceCard.promotion.promotions']}}
{{$productOrderCtrl.translations['antibody.pdp.commerceCard.promotion.viewpromo']}}
{{$productOrderCtrl.translations['antibody.pdp.commerceCard.promotion.promocode']}}: {{promo.promoCode}} {{promo.promoTitle}} {{promo.promoDescription}}. {{$productOrderCtrl.translations['antibody.pdp.commerceCard.promotion.learnmore']}}
产品信息
14251-1-AP
种属反应
宿主/亚型
分类
类型
抗原
偶联物
形式
浓度
规格
纯化类型
保存液
内含物
保存条件
运输条件
产品详细信息
Immunogen sequence: MSAFNLLHL VTKSQPVALR ACGLPSGSCR DKKNCKVVFS QQELRKRLTP LQYHVTQEKG TESAFEGEYT HHKDPGIYKC VVCGTPLFKS ETKFDSGSGW PSFHDVINSE AITFTDDFSY GMHRVETSCS QCGAHLGHIF DDGPRPTGKR YCINSAALSF TPADSSGTAE GGSGVASPAQ ADKAEL (1-185 aa encoded by B C040053)
靶标信息
The protein encoded by this gene catalyzes the reduction of methionine sulfoxide to methionine. This enzyme acts as a monomer and requires zinc as a cofactor. Several transcript variants encoding two different isoforms have been found for this gene. One of the isoforms localizes to mitochondria while the other localizes to endoplasmic reticula.
仅用于科研。不用于诊断过程。未经明确授权不得转售。
生物信息学
蛋白别名: methionine sulfoxide reductase B3; Methionine-R-sulfoxide reductase B3; Methionine-R-sulfoxide reductase B3, mitochondrial; MsrB3; unnamed protein product
基因别名: D430026P16Rik; DFNB74; I-8-23; MsrB2; MSRB3; UNQ1965/PRO4487
UniProt ID: (Human) Q8IXL7, (Mouse) Q8BU85
Entrez Gene ID: (Human) 253827, (Mouse) 320183, (Rat) 680036